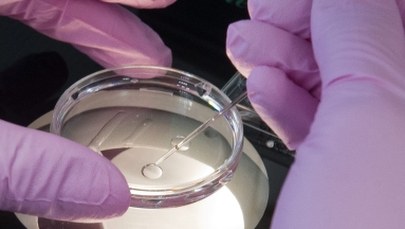
Koniec z finansowaniem procedur in vitro przez państwo

"Wstrzymujemy przyjęcia nowych par do programu in vitro" - usłyszał dziennikarz RMF FM Mariusz Piekarski w rozmowie z szefem kliniki leczenia niepłodności w Białymstoku. To konsekwencja decyzji ministra zdrowia ws. likwidacji finansowania z budżetu państwa tej metody leczenia niepłodności. Konstanty Radziwiłł zapowiedział wczoraj, że rządowy program in vitro zakończy się w czerwcu. W rezultacie tej decyzji wiele par, które są już w rządowym programie, straci szansę na kolejne próby zajścia w ciążę.
Jak wyjaśnia nasz dziennikarz, każda klinika ma określony limit procedur, którymi może dysponować do końca programu, czyli do końca czerwca. Rząd płaci obecnie za trzy próby zapłodnienia metodą in vitro. Jeśli pierwsza zakończy się niepowodzeniem, nie ma pewności, że dana para zdąży do czerwca podejść do procedury drugi albo trzeci raz.
Nie wiem nawet, czy wszystkie (pary) będą mogły skorzystać z tych trzech obiecanych programów. Chyba już nie - przyznaje dr Grzegorz Mrugacz z Kliniki Bocian w Białymstoku.
Pojawia się również problem opłaty za przechowywanie zamrożonych zarodków. Teraz - zgodnie z wymogami programu rządowego - kliniki robią to na swój koszt. Co będzie, kiedy program wygaśnie? Prawdopodobnie kliniki przerzucą koszty związane z przechowywaniem tych zarodków na pacjentów - mówi naszemu dziennikarzowi prof. Rafał Kurzawa ze Szczecina.
Najprawdopodobniej na leczone pary spadnie również cały koszt wykorzystania zamrożonych zarodków, których nie uda się podać kobietom do końca programu.
Program Leczenia Niepłodności Metodą Zapłodnienia Pozaustrojowego, powszechnie zwany rządowym programem in vitro, ruszył 1 lipca 2013 roku i był przewidziany do 30 czerwca 2016 roku. Rząd Ewy Kopacz w ostatnich dniach urzędowania przedłużył program - od 1 lipca 2016 do 31 grudnia 2019 roku. Przeznaczono na ten cel około 304 milionów złotych.
Przedłużenie programu było krytykowane przez PiS. We wtorek zaś nowy minister zdrowia Konstanty Radziwiłł poinformował, że program dotyczący refundacji procedury in vitro będzie kontynuowany jedynie do połowy przyszłego roku.
Dzisiaj rzeczniczka rządu Elżbieta Witek wyjaśniała, że minister zdrowia ogłosił, że "nie odstępujemy od in vitro, odstępujemy tylko od finansowania tego z budżetu państwa". Na razie zmian w ustawie żadnych nie przewidujemy - powiedziała dziennikarzom w Sejmie. Na pytanie, czy od połowy 2016 roku będzie można korzystać z in vitro tylko prywatnie, odpowiedziała, że tak. To nie jest tak, że my zabraniamy, ale mówimy, że nie stać budżetu państwa na to, by finansować to z tych środków, zwłaszcza że poprzednicy pozostawili nam duże braki, jeśli chodzi o budżet - stwierdziła.
Jak zaznaczyła Witek, są inne potrzeby, są Polacy, którzy "są bardzo ciężko chorzy, którzy mają ciężko chore dzieci i którzy muszą je leczyć prywatnie, za swoje pieniądze".
Podkreśliła, że minister zdrowia powiedział, że in vitro nie jest jedyną metodą i "z pewnością będzie informować o tym, jakie są propozycje obecnego resortu zdrowia w tej kwestii".
Odniosła się również do przedłużenia programu przez ministra Zembalę w ostatnich dniach jego urzędowania - zdaniem Witek, Zembala powinien pozostawić to do decyzji nowego ministra. To jest kolejny przykład, jak Platforma Obywatelska, będąc jeszcze u władzy, chciała rozstrzygać kwestie zasadnicze dla władzy, która przyszła po niej, która została wybrana - mówiła Witek.
(edbie)